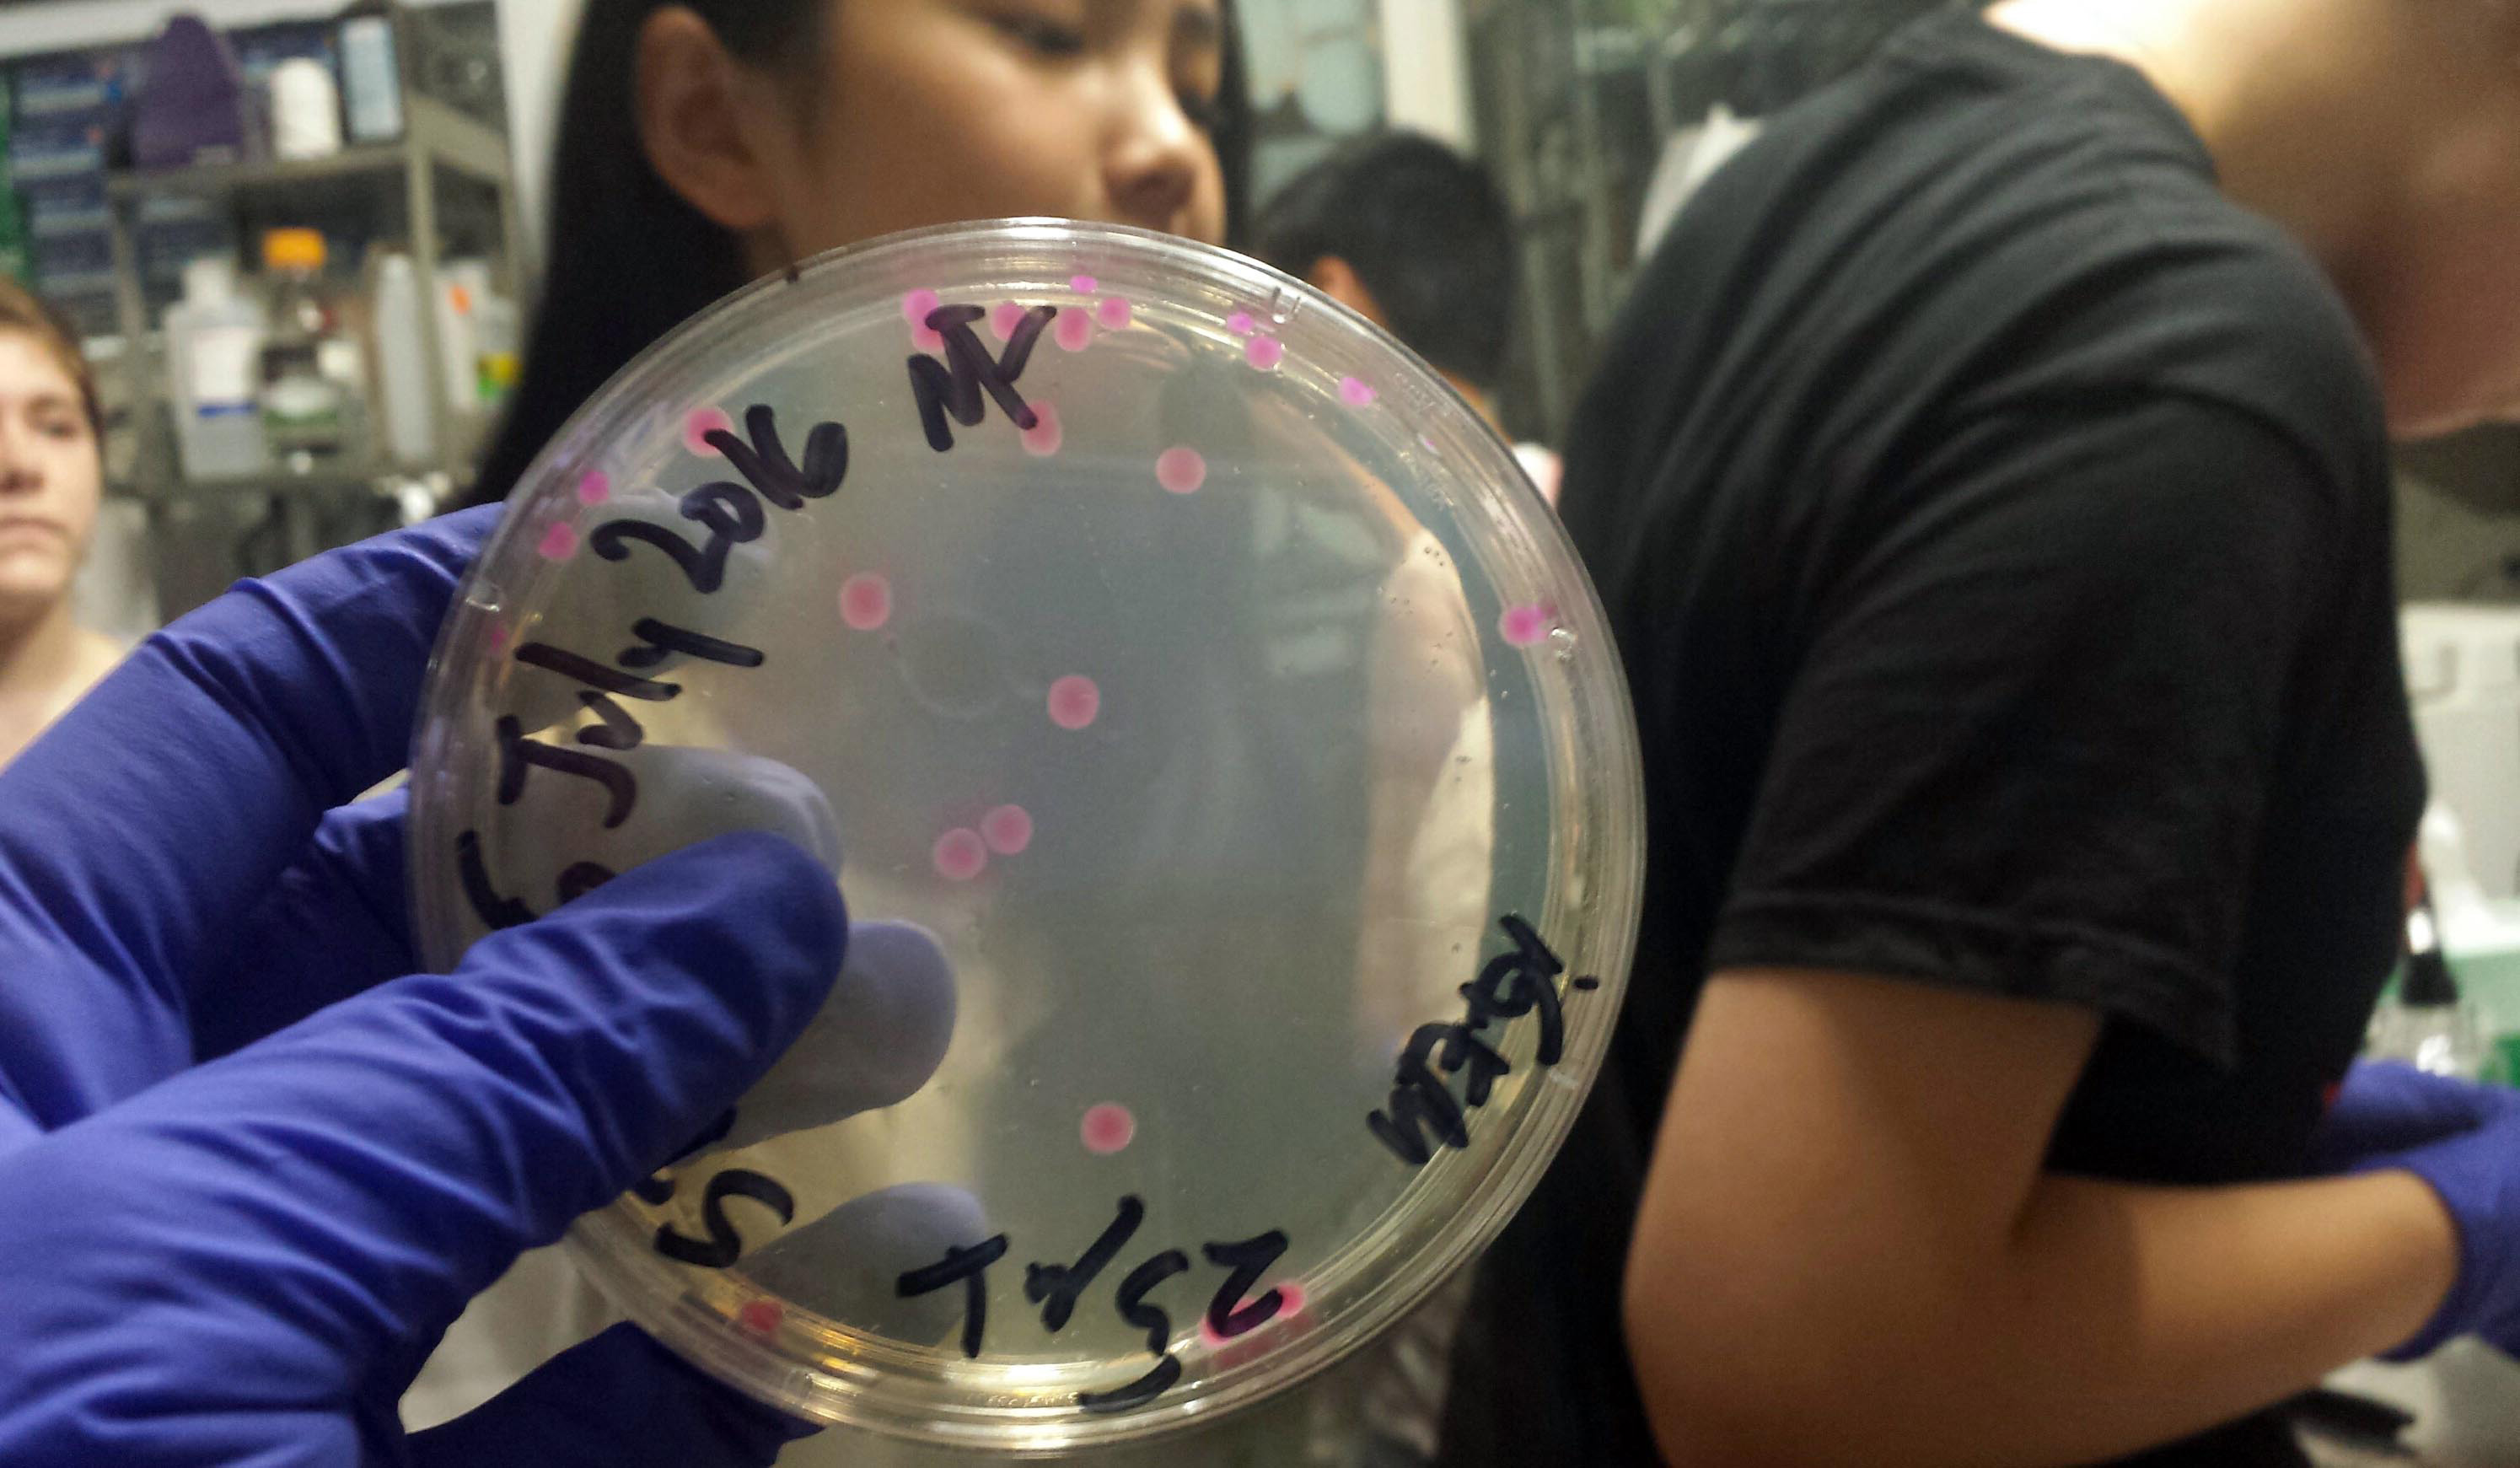

Rutgers STEAM, in New Brunswick, is a growing student-led movement to integrate traditionally-disparate fields and mindsets, broadly in the areas of the STEM fields (Science, Technology, Engineering, Mathematics) and the Arts and Humanities. We aim to develop STEAM as a tool that enables, whether it be by enabling learning, open discussions, product improvements, or new ideas and inventions. In the real world, each of us will have to work alongside those with different skillsets and thought processes, and STEAM emulates both this understanding and teamwork as well as encourages it. It seeks to open those in the STEM fields to more creative branches of thought, and those in the arts to more methodical implementations. These intersecting areas will be the hub that will drive forward innovation, manifested through discussions, workshops, projects, trips, and other events, all of which will showcase how these integrations can work alongside one another to solve problems, explore ideas, evaluate beauty in its different abstractions, and above all, make a difference.
We at Rutgers lie on a breeding ground for STEAM-centric innovation. As a research university, we are dedicated to seeking answers to “what if” questions. An open supporter of diversity, Rutgers is home to different schools in the arts, the sciences, and engineering. Each houses a specialized “small-school” environment in a large-school setting that enables many students to focus on a specific discipline but to still be able to converse and interact with others of radically different backgrounds in a shared space. Through current research thrusts, such as Polynomiography and Musical Technology, as well as other creative spaces, such as the Makerspace and Hackerspace, we are already on our way to democratizing STEM, the Arts, and the new area of STEAM. Based close to NYC, we can also easily access various art and Science-Art hubs that are developing in the city to fuel our projects. We at Rutgers STEAM have access to tools and are creating means that not only enable answers but prompt further questions for exploration.
What is STEAM for Rutgers?
Rutgers is divided into different schools and sub-campuses, and as a result, microcosms of each specialty field have formed and become very isolated in their work and ideas. This has resulted in students reporting they feel siloed in their major or unsure of how to expand their technical and interpersonal skills outside of their field’s traditional domains. Thus, for our first semester, our first main goal was to break those barriers and create a culture for our members to freely experiment with new fields and interact with different majors. Our second main goal was to showcase the different combinations of those fields already present at Rutgers and beyond through hands-on workshops and talks.
As we close for the year, we asked some of our current Board what STEAM is for them, as both an organization and as a movement:
Danica (President & new STEAM x Technology Head):
“Founding a STEAM chapter, for me, came originally from a place of discomfort. As a computer engineer and artist, I felt there were no outlets around that mutually respected the left-brain and right-brain beauty of each of my fields of interest. My experiences in engineering seemed coldly pragmatic, and my experiences in the arts seemed unappreciative of the details of complicated engineering systems. I began noticing that my art show submissions often sat in the intersection of different fields, like interactive art, technology, social justice, and optics. Whenever I learned a new concept, I enjoyed integrating my understanding and appreciation of it in a wholly expressive, but technologically-complex way. So I searched for a community that wanted to explore STEM through more culturally-aware means, and once I found the STEAM University network, I knew I wanted to be a part. I’m grateful for STEAM for enabling me to meet people who validate utilizing the whole-brain to consolidate ideas in more interesting, impactful ways.”
Brian (Treasurer & STEAM x Math Head):
“A lot of my personal projects involve either applying mathematical thinking as inspiration for artwork or leveraging creativity to present abstract technical topics in visually intuitive ways. Until I joined up with STEAM, however, most of these projects didn’t have much scope beyond my own enjoyment. This in mind, I think an important aspect to STEAM is its potential to bring relevance and exposure to these types of creative projects that don’t fit neatly into any other organization’s range of interest. Connecting like-minded people by contributing to STEAM has afforded myself and others a platform to showcase interesting projects that might otherwise be left unshared.”
Samvitha (Secretary & STEAM x Science Head):
“STEAM club was intriguing for me because I, as a biochemistry major, wanted to promote STEM education and encourage others to get interested in STEM. I especially wanted others to know that the STEM fields were not as rigid as traditionally believed and actually involved and invoked a lot of creativity. To me, originally STEAM was a way of identifying the artistic nature of science, but through our past events, I learned that STEAM is not just about combining art and science, but rather it is about finding the unique and intertwined concepts for both fields. It’s about finding the hidden areas in which those intersections come naturally. I hope that through our club, we can spark interest in others to think creatively and explore new ideas.”
Nicole (STEAM x Society Head):
“STEAM is a club where you can think freely and get a taste of fields you wish to collaborate with but might not have thought you could otherwise. If it weren't for STEAM, I don't believe I would’ve met so many different individuals in such fascinating fields, and it not only furthered my understanding of my own sub-disciplines but drove me to work with various distinct mindsets. STEAM is meant for the individuals with an appreciation for differing perspectives and a passion in a broad vision of the world. It also enables people to create what otherwise they would not have the specialty in to complete. STEAM can change the world by simply reminding our work-culture that not only do we need to appreciate an artistic mind, but work collaboratively, for better well-rounded innovations.”
Recap
Rutgers STEAM had a wonderful first semester this past Spring 2016!
Kickoff - Glowstick Dissection
The organization introduced STEAM and its future goals, and we jumped into an activity discussing the chemical composition of illumination, linking and quantifying the beauty to the reactions happening at the molecular level. We then dissected glow sticks and poured the chemicals into petri dishes, transforming the dishes and chemicals into our canvas and paint. We each put on lab goggles and gloves and had fun illuminating the room.
Protein Coloring Book - Workshop
Rutgers Biochemistry professor Dr. Peter Kahn discussed his work on a children's book he made showing real protein structures from his research and encouraged artists to transform them into creatures based on their function, such as a “cellulase chomper.” During the meeting, he gave an introduction on proteins using 3D visualizations and had members make their own protein creatures. We had various creatures, like the superhero “SuperOxide Girl,” decorating the tables. STEAM hopes to bring the activity to nearby elementary schools to teach about biochemistry.

Protein creatures with Dr. Peter Kahn.
Glitch Art - Workshop
We held a workshop discussing the artform of glitch art, with questions such as “Is it art if done by a computer?” and "Is it glitch if we can direct its output?” This delved into learning about image compression techniques and data. We then began an activity to make our own glitch art creations using databending and pixel sorting techniques, then showcased them on an Apple TV by having members bluetooth them up!

Glitch art.
Teaching a Computer to Be A Visual Artist - A Talk with Babak Saleh
Rutgers researcher Babak Saleh has received worldwide attention for his “controversial” research on a computer algorithm that can "not only trace artistic influence but quantify creativity." We invited him to speak on the basics of computer vision. He then showcased some of his findings on both fine arts and graphic design, which included connections not even art historians have found, and shared his programmatic definition of “creative”: artwork with small “scores of influence” from other art and a high score of “influence” in successive works of art. Through his computations, he was able to accurately pinpoint innovators of certain artistic periods and even reasonably suggest how to help make artworks more creative.

Teaching a Computer To Be A Visual Artist, with Babak Saleh.
The Math & Science of Pixar
“Pixar in a Box” is an education collaboration effort between Pixar and Khan Academy illuminating the STEM behind computer animation. We invited Tony De Rose, lead Pixar researcher, and Brit Cruise, a content creator at Khan, to speak on the project and go through an animation exercise on interpolation. We learned about how certain concepts are used in animation, such as combinatorics for character design and phoneme modeling. Cruise emphasized the need for other organizations to do these education projects and left us with a message to do good, creative work with your passions.
Creative Coding - Workshop
STEAM held an introductory Processing workshop, teaching basics of 2D/3D drawing, interactivity, classes, PVectors, and importing different libraries, such as those for webcam and augmented reality. It educated non-coders on how much of what we see can be created using code and introduced broader coding concepts and expressions. We invited members to create, and several made games, animations, artworks, and creatures.
Closing - Music Visualization - Workshop
For our last event, STEAM used computer programming to match sound frequencies to certain visuals, such as color frequencies, and turned songs into beautiful animations. We also worked in a concert hall with live musical performances and large banner paper and art supplies for members to create their own visualization/sonification techniques and artwork inspired by the methods!
Moving Forward
Moving forward, Rutgers STEAM has gathered allies with Rutgers art schools and galleries, the Douglass Project (a STEM initiative for women), the Makerspace and Director of Virtual Worlds, Autodesk, activist organizations, and the STEAM initiative for elementary schools in New Brunswick. We aim to expand our reach through different committees: STEAM x Science, STEAM x Technology, STEAM x Mathematics, and STEAM x Society, which together we hope will encompass all of the different facets of STEAM innovation.